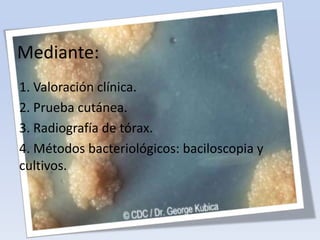
Mediante:
1. Valoración clínica.
2. Prueba cutánea.
3. Radiografía de tórax.
4. Métodos bacteriológicos: baciloscopia y
cultivos.

El documento describe la tuberculosis, una enfermedad infecciosa causada por la bacteria Mycobacterium tuberculosis. Se transmite principalmente a través del aire cuando personas enfermas tosen o estornudan. Los síntomas son inespecíficos pero incluyen tos, expectoración con sangre, sudoración, fatiga y pérdida de peso. El diagnóstico se basa en la clínica, pruebas cutáneas, radiografía de tórax y métodos bacteriológicos. El tratamiento involucra múltiples fármacos como is